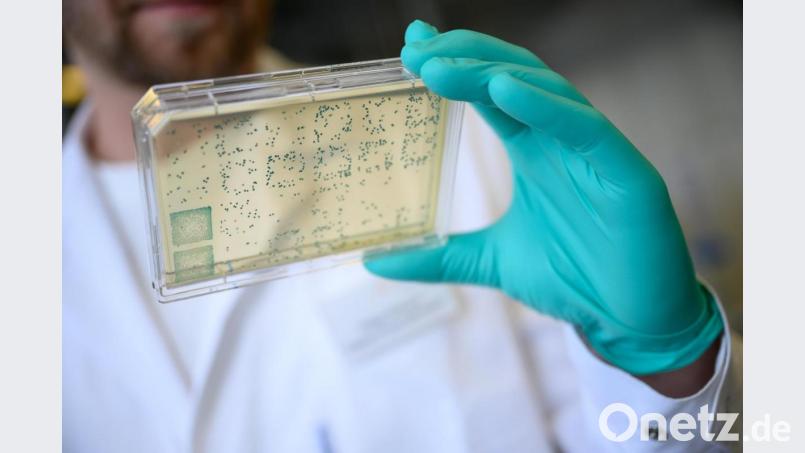
Ein Mann schaut sich in einem Labor des biopharmazeutischen Unternehmens Curevac einen Träger mit Bakterien an, aus denen DNA und anschließend RNA gewonnen wird (gestellte Szene). Bild: Sebastian Gollnow/dpa

Das Robert Koch-Institut in Berlin hat Hoffnungen auf einen baldigen Impfstoff gegen das Coronavirus gedämpft. "Ich persönlich schätze es als realistisch ein, dass es im Frühjahr 2021 sein wird", sagte Präsident Lothar Wieler am Mittwoch. Alles, was bürokratisch machbar sei, müsse getan werden. Klinische Testphasen aber könne man nicht verkürzen. "Wir müssen ein Sicherheitsprofil haben. Impfstoffe können ja Nebenwirkungen haben."
Zuvor hatte Dietmar Hopp, Mäzen des Fußball-Bundesligisten TSG 1899 Hoffenheim und Miteigentümer des Tübinger Pharmaunternehmens CureVac, davon gesprochen, möglicherweise bereits im Herbst einen Impfstoff gegen Sars-CoV-2 liefern zu können. CureVac ist eines der vielen Unternehmen und Forschungseinrichtungen, die weltweit an Impfstoffen arbeiten. "Bei positivem Verlauf könnten wir ungefähr im Frühsommer mit klinischen Tests beginnen", sagte 79-jährige SAP-Gründer der "Bild"-Zeitung.
Wir wären also in der Lage, den Impfstoff im Herbst zu liefern.
Am Wochenende hatte es Berichte und Politikeraussagen gegeben, wonach die USA exklusiv die Rechte an einem Impfstoff von CureVac erwerben wollten. CureVac betonte aber, ein Exklusivvertrag komme nicht infrage. Seit Januar forscht das Unternehmen an einem Impfstoff. Die Europäische Union will die Entwicklung mit bis zu 80 Millionen Euro unterstützen.
Das Biotechnik-Unternehmen war schon 2016 in die Schlagzeilen geraten, weil es vom US-Verteidigungsministerium eine Förderung von rund 33 Millionen Euro erhalten hatte. Binnen weniger Tage hat die Unternehmensführung nun erneut gewechselt. Nachdem Gründer Ingmar Hoerr den hochgelobten Vorstandschef Dan Menichella am Mittwoch vergangener Woche abgelöst hatte, nahm er nun aus gesundheitlichen Grünen selbst eine Auszeit. Hoerr habe aber kein Corona, heiß es am Montag bei CureVac, was am Dienstag in einer Telefon-Pressekonferenz bekräftigt wurde.
Hoerr hatte bereits am Freitag im Interview mit einem Branchendienst betonnt, dass er einen Impfstoff für alle Menschen entwickeln wolle und deshalb an die Spitze zurückgekehrt sei. Er löste Menichella ab, der bei US-Präsident Donald Trump im Weißen Haus am Tisch gesessen hatte. Die Begründung Hoerrs für den Wechsel lautete, CureVac brauche nun keine Unternehmensentwickler wie Menichella sondern einen Wissenschaftler.
Unterdessen hat in den USA ein Freiwilliger testweise einen möglichen Impfstoff injiziert bekommen, teilte die zum US-Gesundheitsministerium gehörenden National Institutes of Health (NIH) mit. Insgesamt nehmen 45 gesunde Teilnehmer an dem Sicherheitstest teil. (mit dpa)

Um Kommentare verfassen zu können, müssen Sie sich anmelden.
Bitte beachten Sie unsere Nutzungsregeln.